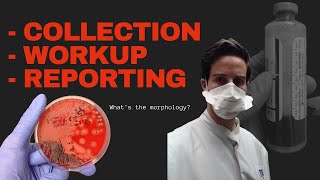

Blood Culture Test Procedure Microbiology video
Online izle ve mp4 mp3 formatlarinda yukle
Videonun muddeti: 3:28
Blood Culture Test Procedure Microbiology videosu mp4 ve mp3 yuklemek ucun hazirdir
Diqqet! Siz Mp4 yukle ve ya Mp3 yukle duymesine basdiqdan sonra eger sistem sizi reklam sehifesine atarsa o zaman derhal geri qayidib emeliyyati tekrar edin ve faylin yuklemek ucun hazir olmasini gozleyin
Videodan Mp4 Yukle
Videodan Mp3 Yukle-1
Videodan Mp3 Yukle-2
Oxshar Axtarishlar
Blood Culture test procedure Microbiology
Blood Culture Collection - OSCE Guide | UKMLA | CPSA | PLAB 2
Blood cultures
Blood Culture Test Procedure - Microbiology
Microbiology: How to perform a Primary Set up from a Positive Blood Culture
Novel Approaches to Pathogen Detection & Sepsis Diagnostics (Session 4 | 5th World Sepsis Congress)
AST and Rapid Bacterial Identification by Blood Culture Pellet | Protocol Preview
Blood cultures: Clinical Nursing Care
Blood Culture Draws- Top Priorities (Nursing Skills)
Video Mp4 Mp3Azwap.Biz
Azwap.Biz 2021-2023